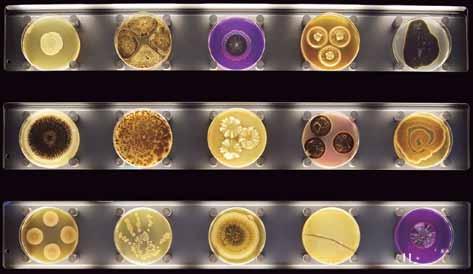

18 de noviembre Año 9 No. 443
Cartelera
Cultural
Página 3
Arte
La genialidad colorida de Vincent van Gogh Página 4
Deportes
Ganadores del Guante de Oro Página 6
Muchas personas pueden identificarse con algún artista específico, por el gusto en el color, la técnica, o lo que les hace sentir, y este es el caso del famoso pintos Vincent van Gogh.

Este genio de la pintura nació en 1853, en la localidad de Zundert, Países Ba jos, y desde 1880 decidió incursionar en el mundo de la pintura, al ingresar como aprendíz en una filial de la galería de arte Goupil; todo esto, gracias al apoyo de su hermano Theo, quien fue el que lo impulsó a seguir ese camino.
Sin embargo, este personaje sufrió tam bién problemas con su salud mental, y fue internado cerca de un año en un hospital psiquiátrico.
Cultura
Palacio Nacional de la Cultura: pilar del arte guatemalteco Página 7
Navidad
Iluminación, cultura y arte guatemalteco Página 10
Ciencia
El museo de los microbios Página 12
Sumario Presentación
Moda
Calvin Klein, el “minimalista creador de deseo” cumple ochenta años Página 14
Muchas personas asocian sus obras a sus estados mentales, tal como sucede con Trigal con cuervos, que fue pintada dos semanas antes de su suicidio. Esta pintura muestra un cielo oscuro y a una bandaba de cuervos cubriendo sus tri gales y atravezando este un camino cor tado. Otro suceso por el que es conoci do es el que ocurrió en 1888, cuando se cortó la oreja izquierda en una discusión.
Sin embargo, a pesar de su inestabilidad, el pintor ha permanecido en el gusto del público hasta nuestros días. Sus obras han sido replicadas en muchos lugares y se han realizado exposiciones por todo el globo terráqueo. Este es el caso de Gua temala, que actualmente cuenta con la exposición Van Gogh, el Sueño Inmersi vo, en la cual se aprecian algunas obras y hologramas del retratista.
DIRECTORIO
Dirección General:
Silvia Lanuza
Coordinación de Redacción: Katheryn Ibarra
Redactores: Marisol Vásquez, Wendy Villagrán y Danilo Ramírez
Diseño Gráfico: Carlos Franco R., Evelyn Silva
Diagramación: Mauro González, Sulhema Pacheco
Digitalización: Freddy Pérez
2
Portada: Van Gogh, el Sueño Inmersivo Fotógrafo: Luis Vargas
Noviembre 2022
viernes 18 sábado 19 domingo
¡Regresemos a 1851 en honor a Rafael Carrera! Un historiador dará a conocer a quién perteneció la casa donde funciona el Centro Cultural Flamingo Histórico y el estilo de vida de la época. Costo de la entrada: Q100 por cada día. Horario: 18:00 a 21:00. Lugar: 8a. avenida 5-17 zona 1. Habrá premios para los mejores tres trajes de la época.

El Festival de las Flores se vivirá en La Antigua Guatemala y es un tributo a la Eterna Primavera. Un equipo de emprendedores pinta los balcones, calles y puertas, así como la decoración de plazas, balcones y parques se podrá observar en la Ciudad Colonial. Más información en el sitio de Facebook @festivaldelasfloresenlaantigua.
A partir de las 8:00 se iniciará este evento deportivo de atletismo para mujeres, en conmemoración al Día Internacional de la No Violencia Contra la Mujer, desde la Plazuela España. Más información, en la página de Facebook Municipalidad de Guatemala



Museo Popol Vuh de la Universidad Francisco Marroquín presenta el Curso, taller práctico y visita: talleres prehispánicos de obsidiana. Horario: 09:30 a 11:30. Más información en el Facebook Museo Popol Vuh, Universidad Francisco Marroquín
Webinar gratuito: Sordera repentina - Diagnóstico y tratamiento, impartido por la especialista en Otorrinolaringología la Dra. Xiomara Amador. A partir de las 18:00. Más información, en la página de Facebook Centro Clínico Cabeza y Cuello.



Estrategias y herramientas para la creación de mapas mentales será transmitido por Facebook Live en la página PEM Tecnología Educativa Umg. A partir de las 18:00.
Blink-182 Tribute será presentado en Rock’ol Vuh (6ª. Av. 1-32, zona 1). Ingreso Q50. A partir de las 20:00 horas.
3 Cartelera C ultural
Guatemala, viernes 18 de noviembre de 2022
20 lunes 21 miércoles 23 martes 22 jueves 24
Obra Autorretrato, que se encuentra en el Museo de Orsay, París.
La genialidad colorida de
Vincent van Gogh

Texto:
Marisol Vásquez
Fotos: Luis Vargas

Vincent van Gogh nació en 1853, en Zundert, Países Bajos, era el mayor de los seis hijos de un pastor protestante. Mantuvo estrecha relación con su hermano Theo, quien sería determinante en su vida y trayectoria artística, ya que, animado por él, en 1880 decidió dedicarse a la pintura.
Ingresó como aprendiz en la filial de La Haya de la galería de arte parisina Goupil, una sociedad de comerciantes de arte fundada por su tío Vincent. Trabajó como profesor, ayudan te de un pastor metodista y empleado de una librería. En 1886 se reunió con su hermano, en París, donde tuvo contacto con el impre sionismo que reorientó visiblemente su estilo.
Pese a su pasión artística, también su salud mental se deterioró con el tiempo, lo que causó que se internara en el hospital psiquiátrico de Saint-Rémy-de-Provence, donde perma neció 12 meses. La pérdida de contacto con
4
noviembre de 2022 arte
Guatemala, viernes 18 de
La paleta de colores del artista neerlandés estuvo impresa de tintes emocionales y el vigor de su pasión interior, que lo convirtió con los años en uno de los genios de la pintura.
la realidad y la tristeza motivaron al desarrollo de un estilo basado en formas dinámicas y en el uso vigoroso de la línea.
En mayo de 1890, se trasladó a París para visitar a Theo. Por consejo de él viajó a Auverssur-Oise, donde fue sometido a un tratamiento homeopático por el doctor y pintor aficionado Paul-Ferdinand Gachet. En este pueblo retra tó el paisaje y a sus habitantes, para intentar captar su espíritu.
A pesar de su lucha personal y artística, el 27 de julio de 1890, en los campos, Van Gogh se disparó en el pecho; murió dos días más tarde. A los seis meses, le siguió su hermano, que está enterrado a su lado en el cementerio de Auvers, según la página Biografías y Vidas.

Su legado eterno
Noche estrellada (1889, MOMA, Nueva York)
Una proyección aún más intensa de su estado de ánimo, ya que en el paisaje se aprecian las ondulaciones que son una visionaria repre sentación del cielo, reflejo de una abrumadora angustia interior. Esta obra le ha valido al ar tista la consideración de genial precursor del expresionismo.
Autorretrato (1890, Museo de Orsay, París)
El pintor le regaló este autorretrato al doctor Gachet. El predominio de los tonos azules contrasta con los rojos y naranjas del pelo y el rostro; azules son también los ojos, cuya mirada fija y penetrante atrae de inmediato la atención del espectador.
Los girasoles (1888, National Gallery, Londres)
La obra formaba parte de una serie destinada
VanGogh, el Sueño Inmersivo
Actualmente, se encuentra en Guatemala esta exposición digital, ubicada en El Bedford, Dinamia Cayalá, zona 16. Ahí puede apreciar los icónicos cuadros del artista en una galería itinerante que reúne más de 75 obras que podrán vi sualizarse a través de multiproyecciones a 360° de imágenes digitales y una sala con hologramas para conocer su biogra fía, narrada por sí mismo.

a decorar el estudio donde trabajaban juntos Van Gogh y Paul Gauguin. En algunos de los lienzos, las flores están colocadas sobre un fondo azul pero, en este, todo está pintado en distintas gamas de amarillo, color que en el ar tista se asocia con la luz del sol y la felicidad.
La habitación de Van Gogh en Arlés (1889, Museo de Orsay, París)
Representa el dormitorio del pintor, tema que trató en varias ocasiones con el deseo de ex presar la idea de un “completo descanso” a través del uso de colores claros y empasta dos. Mostró el ambiente de la pieza, amue
arteblada con una cama, una mesa, dos sillas, un espejo, varios cuadros y dos dibujos. Una de las versiones de este lienzo la terminó en 1889, durante su estancia en el asilo de SaintRémy-de-Provence.
Trigal con cuervos (1890, Museo Van Gogh, Ámsterdam)
Dos semanas antes de su suicidio, pintó una de sus obras más conmovedoras, que ha sido objeto de muchas interpretaciones. Un premonitorio cielo oscuro con una ban dada de cuervos cubre uno de sus amados trigales, atravesado a medias por un camino cortado.
Guatemala, viernes 18 de noviembre de 2022
5








6 Guatemala, viernes 18 de noviembre de 2022 deportes
En Qatar 2022 se hará entrega del Guante de Oro número 8 al mejor arquero del Mundial; los 7 anteriores fueron otorgados entre las ediciones de 1994 y 2018. Ganadores del Guante de Oro EE. UU. 1994 Michel Preud'homme (Bélgica) Francia 1998 Fabien Barthez (Francia) Partidos jugados Partidos ganados Goles recibidos # # # 4 2 4 7 7 6 5 2 2 7 6 2 7 6 4 7 6 6 7 5 3 Posición final #11 (octavos) Posición final Campeón Posición final Campeón Posición final Campeón Corea-Japón 2002 Oliver Kahn (Alemania) Alemania 2006 Gianluigi Buffon (Italia) Posición final Subcampeón Posición final También Balón de Oro Sudáfrica 2010 Iker Casillas (España) Brasil 2014 Manuel Neuer (Alemania) Rusia 2018 Thibaut Courtois (Bélgica) Infografía: EFE
Los 7 Galardonados
Danilo Ramírez Textos y fotos
Palacio Nacional de la Cultura: pilar del arte guatemalteco

La joya arquitectónica que representa al Gobierno arriba a 79 años de existencia. Inaugurado el 10 noviembre de 1943, en el cumpleaños 65 del entonces presidente, Jorge Ubico, y fue ideado para albergar las oficinas gubernamentales; ahora es un edifi cio que resguarda una importante colección de arte y un ícono del Centro Histórico, imper dible para los turistas.
Con su estilo único, una combinación de ar quitectura colonial con influencia francesa y neoclásica, conocida como barroco o renaci miento español, posee cientos de detalles en cada esquina, pasillo o columna. Cada espe cificación arquitectónica o artística posee un plano, los cuales se encuentran en resguardo en la pinacoteca del recinto.
Restauraciones
La joya arquitectónica, diseñada por Rafael Pérez de León, Enrique Riera y Ángel Rodas, fue declarada monumento histórico en no viembre de 1980. Durante los últimos años se han realizado varios trabajos de restauración de este importante sitio. Este año destacan la reparación de muros internos así como la recuperación de los frescos en el primero y segundo nivel, esta última, a cargo de 30 ar tistas. “Para llegar a hacer los colores a veces
7 Guatemala, viernes 18 de noviembre de 2022 cultura
cultura
nos llevamos hasta ocho diferentes tonos para poder llegarle al original; siempre se respetan las luces para evitar falsos históricos”, indica Luis Pérez, encargado del equipo de restaura ción de los frescos.

El color del edificio es “una historia de amor”, según Daniel Orozco, administrador del Pala cio. “El color favorito de la esposa del señor Ubico, Marta Lainfiesta, era el verde; con base en su gusto, el edificio es de este tono”, añade.
Curiosidades
• El Palacio Nacional de la Cultura cuen ta con 350 oficinas.

• En cada puerta del edificio se encuen tra una réplica de la huella dactilar de Jorge Ubico.
• Ubico tenía un gusto por el número 5, el cual se puede encontrar en varios de talles del recinto.
• El Palacio es básicamente tres edifi cios en uno, pues está hecho en bloques, lo que lo hace antisísmico.


• Los murales de Alfredo Gálvez Suárez, que están colocados sobre las gradas principales, fueron llevados a pie, desde su taller en la zona 13, para evitar que fueran dañados por el movimiento de un vehículo.
• Recibe alrededor de 26 mil turistas al año.
Puede hacerse un recorrido virtual escaneando acá
8
Guatemala, viernes 18 de noviembre de 2022




9 cultura
Guatemala, viernes 18 de noviembre de 2022
Iluminación, cultura y arte guatemalteco
 Texto: Wendi Villagrán Fotos: Mario León
Texto: Wendi Villagrán Fotos: Mario León
Diversidad de figuras iluminará la Plaza Berlín en las fiestas de fin de año.
El alumbrado navideño es parte de las tradiciones y costumbres de los guate maltecos y representa la unión de las familias, tiempo donde se enciende el espíritu de la temporada de fin de año en diferentes áreas en el ámbito nacional.
Para ser parte de esta magia la Empresa Eléc trica de Guatemala (Eegsa), por segundo año consecutivo, iluminará la Plaza Berlín el 25 de noviembre, a las 18:00; este año, el atractivo será un concepto innovador y cultural, con fi guras propias de la cultura maya.
Victoria Balcárcel, de la Unidad de Gestión Social de Eegsa, explicó que tanto la idea del proyecto y el material para la elaboración de las estructuras es traído de Medellín, Colom bia. País que también facilitó capacitaciones para la fabricación imágenes.
Balcárcel destacó que otro propósito es dar la oportunidad de empleo por 8 meses a 30 per sonas del municipio de Chinautla, lugar donde se encuentra el taller de trabajo. El personal está dividido en 20 artesanas y 10 soldadores. Los trabajadores refieren que la iniciativa es una bendición para muchos hogares del área.
10 Guatemala,
18 de noviembre de 2022
viernes
navidad
Este es el caso de Ismari Díaz, madre un niño de 3 y una niña de 6 años, quien detalló que nunca imaginó aprender a hacer ese tipo de arte y que pudiera ser admirado durante una época tan especial.

“Espero en Dios que el proyecto siga por más años, porque es de gran ayuda económica para nuestras familias”, afirmó Díaz.
Por su parte, Carlos Alvarado manifestó que antes tenía trabajo temporal en herrería y aho ra cuenta con un empleo fijo, y eso ha benefi ciado la economía de su hogar.

navidad

La elaboración de las figuras puede llevar desde 2 a 3 semanas, según el nivel de complejidad.
La iluminación también se realizará en Chinautla, Santa Catarina Pinula, Puerto San José y Sipacate, en diferentes días.
11
Guatemala, viernes 18 de noviembre de 2022
El museo de los microbios
 Texto: Daniel Galilea/EFE Fotos: EFE
Texto: Daniel Galilea/EFE Fotos: EFE
En la ciudad de Ámsterdam (Países Bajos) se encuentra el museo Micropia.
Los microbios son una de las formas de vida más numerosas en nuestro planeta, nos ro dean a cada instante, están presentes en todas partes, incluido nuestro propio cuerpo y, continua mente, salen a la luz nuevas especies microbianas desconocidas.
Estos seres diminutos comen casi de todo, inclui dos metales, ácidos, petróleo y gas natural.
Durante mucho tiempo, los científicos pensaron que la naturaleza estaba compuesta únicamente por los organismos que son visibles a simple vista, como árboles, plantas o algunas aves.
Hoy sabemos que dos tercios de la vida en la Tie rra son microorganismos que no se pueden ver sin un microscopio.
Amigos benefactores
Los microbios están en todas partes. Al igual que nosotros, ningún animal o planta puede existir sin estos benefactores invisibles. Por ejemplo, el ca racterístico color rosado del ave flamenco es debi do a estos organismos.
Las microalgas del océano producen la mitad del oxígeno de nuestra atmósfera; los hongos y las bacterias convierten la materia orgánica de los ani males muertos en materias primas; las bacterias intestinales nos ayudan a digerir los alimentos... Resumiendo, sin estos seres la vida en la Tierra no sería posible.
El número de microbios que lleva una persona en su cuerpo es miles de veces mayor que el de los habitantes del planeta, y diez veces mayor que el de las células que componen el cuerpo humano. En conjunto suman aproximadamente 1.5 kilos de su peso corporal.
Sin embargo, hasta hace poco no existía ningún lugar donde el público pudiera descubrir y obser var en vivo y en directo a estos organismos vivos solo visibles al microscopio, entre los que figuran los virus y las bacterias, y que con frecuencia la
Con el escaneo corporal descubres tus propios microbios.
CIENCIA
Guatemala, viernes 18 de noviembre
de 2022
12
gente asocia de modo exclusivo con la suciedad y las enfermedades.
Las carencias, tanto de un espacio físico para ex poner públicamente los microbios, como de una perspectiva más positiva sobre esos seres con una organización biológica elemental, se ha subsana do en parte con la apertura en Ámsterdam (Países Bajos) de Micropia, el primer museo del mundo de dicado a los microbios.

En este espacio, niños y adultos descubren que, si bien algunos microorganismos pueden enfer mar a personas, animales y plantas, la mayoría de los microbios no son nocivos y muchos juegan un papel clave en la biosfera (conjunto de los seres vivos del planeta y medios donde se desarrollan), por ejemplo al producir oxígeno o descomponer la materia orgánica.
En Micropia, los visitantes pueden observar imá genes tomadas bajo el microscopio y ampliadas miles de veces (tanto en fotos como en video) de cientos de microorganismos de todo el planeta, en muchos casos llamativos, como la Noctiluca scinti llans, conocida como chispa de mar, un microrga nismo que produce bioluminiscencia, al igual que las luciérnagas.
Los visitantes del “museo de los microbios” tam bién pueden ver imágenes de Volvox aureus, un alga verde microscópica de forma esférica que ha bita en aguas dulces formando colonias y que está presente en el planeta desde hace más de 200 mi llones de años, es una de las formas de vida más antiguas de vida que se conoce.


La Volvox aureus es una de las “estrellas” de Mi cropia, ya que sus colonias fueron registradas por primera vez por el microscopista holandés Antonie van Leeuwenhoek, en 1700, y hoy se estudian am pliamente como un modelo para investigar cómo los organismos desarrollan células y tejidos especializados y rastrear la evolución de la vida multicelular y los animales superiores.
Guatemala, viernes 18 de noviembre de 2022

Pared con 150 placas de Petri, con diferentes microorganismos.
La Noctiluca scintillans produce efectos de luz en las olas.
Microalga Volvox aureus.
13 CIENCIA
Técnicos cultivan microorganismos en el laboratorio.
Calvin Klein, el “minimalista creador de deseo”, cumple ochenta años
Texto: Begoña de la Fuente/EFE Fotos: EFE
Hoy, a punto de cumplir 80 años, el di señador Calvin Klein pasa sus días en su Nueva York natal, donde lleva una intensa vida social. Mientras, la goma con su nombre, que remata las prendas íntimas de la marca, sigue acompañando a generaciones.

Con 26 años crea su propia mar ca y abre una tienda en la Séptima Avenida, en la que el minimalismo de sus prendas, con sus líneas lim pias y colores neutros, pronto cauti va a público y crítica. Con 27, ya se habla de él como el Yves Saint Lau rent norteamericano, y con 30, reci be el tercer Premio Coty, que viene a ser como el Oscar de la moda.
El espaldarazo definitivo no le lle ga sino hasta la década de 1980 cuando irrumpe en el mercado de los vaqueros. “Es divertido ver mi etiqueta en el trasero de alguien; eso me gus ta”, comentó en una ocasión, y en el de la ropa interior, donde sus piezas andróginas rivalizan con la lencería de encaje y el célebre Wonder bra, tan de moda entonces.
14 Guatemala, viernes 18 de noviembre de 2022 moda
Si por algo es conocido
Calvin Klein, es por sus vaqueros “de marca” y por su ropa interior.
Calvin Klein (i) y la diseñadora Donna Karan.
Nada hubiera sido igual, sin embargo, si sus colecciones no hubieran venido acompaña das de una peculiar manera de entender la publicidad basada en unas campañas su gerentes, para unos, o agresivas para otros, pero de fuerte impacto en el espectador.
De los vaqueros de Brooke Shields al modelo embarazado Todo empezó en 1980 cuando, en un anuncio dirigido por el fotógrafo Richard Avedon, una jovencísima y sugerente Brooke Shields, de 15 años, enfundada en unos ceñidos vaque ros, pronunciaba la famosa frase: “¿Sabes lo que hay entre mis Calvin y yo? Nada”.
Las imágenes encendieron la moral de los sectores más conservadores y fueron prohi bidas en cines y en varias cadenas de tele visión. Pero tuvieron tal éxito, provocado en parte por la controversia creada, que no hay colección que desde entonces no vaya unida a una sugestiva campaña publicitaria.
Son muchos los modelos y artistas que han confiado en Calvin después de ello, empe zando por Kate Moss o Mark Wahlberg (“La mejor prevención contra el Sida es dejarte los Calvin puestos”, alegaba el actor), catapulta dos ambos al éxito por la marca; pasando por íconos adolescentes como Justin Bieber o la colección Erótica de 2016, protagonizada por Kendall Jenner, y concluyendo con el cantante latino Maluma.
Guatemala, viernes 18 de noviembre de 2022
Su última campaña, This is love, es un home naje a la inclusión y la diversidad sexual. En ella aparece Roberte Bete, un modelo trans brasileño, que posa embarazado junto a su pareja, Erika Feeh, en la cama. “Muy Calvin” también.
Hoy, al cumplir 80 años, los celebra el 19 de noviembre, sigue disfrutando de una intensa vida social en su Nueva York natal, solo o en
Las campañas publicitarias de la firma Calvin Klein son historia del mundo de la moda. En la imagen, una valla publicitaria que ocupa cinco plantas en un edificio del barrio neoyorquino del SoHo.

compañía. Casado en dos ocasiones, en 1964 contrajo matrimonio con su compañera de es tudios Jayne Centre, con quien tuvo a su hija, Marci Klein, que fue secuestrada cuando tenía 11 años por su niñera. En 1986 se casó por segunda ocasión; esta vez, con Kelly Rector, relación que concluyó en 2006. Entre 2010 y 2013, mantuvo un romance con el joven actor porno Nick Gruber, momento en el que reco noció abiertamente su homosexualidad.

15
moda
Modelos lucen creaciones de la firma Calvin Klein.


GENERAL
de las figuras más prominentes de la política guatemalteca del siglo XIX. carlo es remitirnos a la reforma liberal 1871, movimiento de cambios y renovaciones en estructuras sociales, económicas y políticas de la Colonia. Pensar solo en el caudillo, implica el olvido del ser humano detrás la gesta de su tiempo. Tipografía Nacional 18 calle 6 - 72 zona 1 PBX:1590 ext.112 Q50
DEL
MIGUEL GARCÍA GRANADOS MEMORIAS Una































 Texto: Wendi Villagrán Fotos: Mario León
Texto: Wendi Villagrán Fotos: Mario León



 Texto: Daniel Galilea/EFE Fotos: EFE
Texto: Daniel Galilea/EFE Fotos: EFE